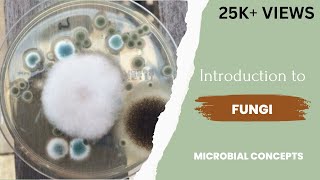

Introduction to Fungi
Maureen Richards Immunology & Microbiology
Introduction to Mycology
This is an educational video.
Microbiology Department
Introduction to Mycology
اسم المساق: أحياء دقيقة طبية تشخيصية اسم المحاضر: د. عبد الرؤوف المناعمة. مشرف الموقع : أ. خالد محمد الأدغم الكلية: العلوم الصحية القسم: العلـوم الطبيـة المخبرية وصف ...
IUG Video Lectures
Introduction to Fungus
Class notes.
Craig Savage
Mycology 101-Citizen Science
In this video, we will go through the steps most commonly utilized by professional and amateur mycologists to identify unknown specimens. We also describe ...
Fresno Mycology Society
Fungi: Death Becomes Them - CrashCourse Biology #39
Death is what fungi are all about. By feasting on the deceased remains of almost all organisms on the planet, converting the organic matter back into soil from ...
CrashCourse
Mycology Introduction
Adnan Jaran
Mycology Part 1: Introduction to mycology: Difference between fungi and bacteria: Dr. Tanmay Mehta
Mycology Part 1: Introduction to mycology: Difference between fungi and bacteria: Dr. Tanmay Mehta.
Q world Medical Education
Microbiology 577 a Mycology Introduction Fungi Fungal Types Classification Yeast Mold disease
Mycology, fungi,what are fungi,ergosterol,chitin, fungal,mushroom,classification,morphological,yeast, Cryptococcus,neoformans,pathogenic,Saccharomyces ...
MBBS VPASS
Mycology I: General Introduction and Dimorphic Fungi - Dr. Morgan (Cedars Sinai) #MICROBIOLOGY
Mycology I: General Introduction and Dimorphic Fungi - Dr. Morgan (Cedars Sinai) #MICROBIOLOGY.
pathCast
4.1. Introduction to Mycology-I - Medical Mycology
This series of videos contains complete classroom lectures on medical microbiology, immunology and parasitology for medical students. Visit our website for an ...
Dr. Prodigious
Introduction to Mycology
Description about Fungi and characteristics.
Dr. Karash: Learning Point
Introduction to fungi | Fungus
This video contains basic information about fungi,their characteristics, structure, reproduction, importance and some pathogenic examples. Find links for other ...
microbial concepts
Intro to mycology
benz edogawa
Introduction to Mycology
Nicole Dutton
Mycology Part 3: Introduction to mycology: Systemic classification of fungi: Dr. Tanmay Mehta
How fungi reproduce? What is spore ? What is conidia ? Are spore and conidia same thing ? what are the types of spores ? What is lower fungi ? what is higher ...
Q world Medical Education
Introduction to Mycology
A simple introduction to the scientific study of fungi. I mainly discuss the fungal life cycle and parts of a mushroom. I do not own the rights to most of the ...
Mycelia Mike
General Microbiology 11-INTRODUCTION TO MYCOLOGY & BASIC IMMUNOLOGY I | Dr Eisa S Omar
المحاضرة الحادية عشر 1️⃣1️⃣ في علم الاحياء المجهري لدكتور عيسي صالح عمر ⚕️ مقدمة في علم الفطريات وعلم المناعة الأساسي العنوين المشروحة: الشيتات يلي ...
أطباء المستقبل - Future Doctors
Classification and Structure of Fungi (Fungal Infections - Lesson 1)
An overview of a practical classification scheme for pathological fungi, as well as a summary of their microscopic structure. Differences between yeast and mold ...
Strong Medicine
سلسلة محاضرات كورس علم الفطريات Mycology - محاضرة 1 (Definition and general characters)
لمشاهدة كورس علم الفطريات كامل اضغط هنا http://cutt.us/5zOo4 ------ لو بتعرف تشرح كورس معين متكسلش تبقي واحد مننا وتشاركنا الفكرة عشان تستفيد وتفيد غيرك ...
SCI GEEKS
Mycology Part 2: Introduction to mycology: Morphological classification of fungi: Dr. Tanmay Mehta
Mycology Part 2: Introduction to mycology: Morphological classification of fungi: Dr. Tanmay Mehta Learn about various classes of fungi including yeast, yeast ...
Q world Medical Education
Introduction to Fungi | مقدمة في الفطريات
إستجابة لرغباتكم أحبتي تفضلوا مقطع "مقدمة في الفطريات" كأول حلقة في سلسلة علم الفطريات الطبية وللمزيد تفضلوا سلسلة اسرار التفوق الدراسي ...
د.محمد آل قمبر
The Magic Of Mushrooms Mycology BBC Documentary
Jim Resendez
Introduction to medical mycology in hindi
This video contains the general introduction of medical mycology. Definition classification Diseases.
Kamal Dhariyal
Introduction to Fungal Phylogeny and Taxonomy
There are a lot of species in the fungi kingdom. How many? Over five million! That's a lot of fungus to sort through, so how do we keep things organized? Well we ...
Professor Dave Explains
فطريات نظري lec 1 / Introduction to Medical Mycology
أرواح ملكوتية
Mycrobiology - Introduction to Mycology Part 1
YBU TIP
MYCOLOGY- Introduction | Fungi| Somatic structures
In this video, I have discussed about features of Fungi, different somatic structures of Fungi, types of thallus, specialized structures formed by plant pathogenic ...
Jhumishree Meher
Introduction to mycology
BVDU Microbiology
Introduction to Clinical Mycology: Part 2 [Hot Topic]
Our speaker for this program is Dr. Glenn Roberts, a Professor of Laboratory Medicine and Pathology, and Microbiology as well as a consultant in the Division of ...
Mayo Clinic Laboratories
introduction to mycology
mariya cf
General Microbiology 10- INTRODUCTION TO VIRUS & INTRODUCTION TO MYCOLOGY | Dr Eisa S Omar
المحاضرة العاشرة في علم الاحياء المجهري لدكتور عيسي صالح عمر ⚕️ مقدمة عن الفيروسات و مقدمة عن علم الفطريات العنوين المشروحة: الشيتات يلي يشرح منهن ...
أطباء المستقبل - Future Doctors
General Mycology video
محاضرة قسم الميكرو كلية الطب جامعة بنها.
Faculty of Medicine Benha University Channel
INTRODUCTION TO MYCOLOGY
INTRODUCTION TO MYCOLOGY, YEAST, YEAST LIKE, DIMORPHIC.
MICROBIOLOGY Notes
History of Mycology Part 1
In this video, i explained about the important contributions made by the distinguished mycologists for the evolution of mycology as a subject upto 19th century..
Plant Pathology with Dr. NS
Introduction to mycology/Fungi/Fungal Morphology
Mycology #FungalMorphology #Mushrooms The video contains information about mushrooms. The study of mushrooms is called mycology.
Science For Daily Life
Medical Mycology- General Introduction, Classification & Dimorphic Fungi
Medical Mycology in different sections. In the next video we will learn about Superficial Mycoses. So stay connected & watch the complete video for better ...
MY DOCTORS
Introduction to Mycology
Mycology and Plant Pathology.
Science Hub
Mycology Microbiology|What is Mycology|Fungi|Fungi Characteristics|Saprophytes|Fungi Mycology
mycology microbiology|what is mycology|fungi|fungi characteristics|saprophytes| fungi mycology.
Last Night Study
Introduction to Medical Mycology
علم الفطريات Introduction to Medical Mycology.
الطريق الى النجاح
Dr. A.M. Ebabhi. BTN 303 Introduction to Mycology
Unilag Blended Learning
MMI11 Introduction to Mycology
MBBS 2010